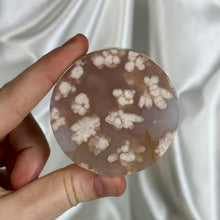
Load image into Gallery viewer, Flower Agate Pedestal Carving G

Listing is for pictured crystal. Flower Agate is an Agate with beautiful plumes that mimic the look of flowers. It represents nurturing and femininity. Please note any surface “imperfections” such as cracks/chips/scratches/caves that are common in natural crystals and may be present.
Please read policies before placing your order - all sales final! Shipping insurance for your order is available at checkout via Route shipping insurance - as a small business we do not offer refunds on lost or damaged packages, which is why we offer this affordable third party protection option for orders of any size 🤍